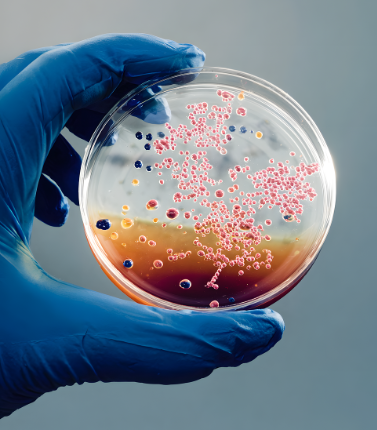

STEAM klub pro středoškoláky z Jihomoravského kraje.
Informace na https://www.jcmm.cz/steam-kluby-pro-zaky/temata
STEAM klub je realizován a financován v rámci projektu „Implementace DZ JMK“ v rámci Operačního programu Jan Amos Komenský, který je financován Evropskou unií, státním rozpočtem ČR a Jihomoravským krajem.